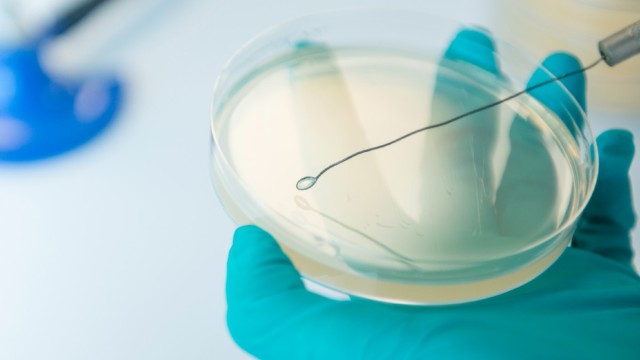

Faculty of Health and Medical Sciences
We are comprised of five schools, all working under a 'One Health' vision, to provide interdisciplinary research and teaching in human and animal health.
Events
Our staff members
Professor Roberto La Ragione
Interim Pro-Vice Chancellor Executive Dean for FHMS
Roberto graduated in 1995 and then went on to study for a post graduate degree in veterinary microbiology at the Royal Veterinary College (University of London). In 1996 he moved to the government's Veterinary Laboratories Agency (VLA) to undertake a PhD on the pathogenesis of E. coli in poultry. On completion of his PhD studies, Roberto commenced a post-doctoral position at Roy...